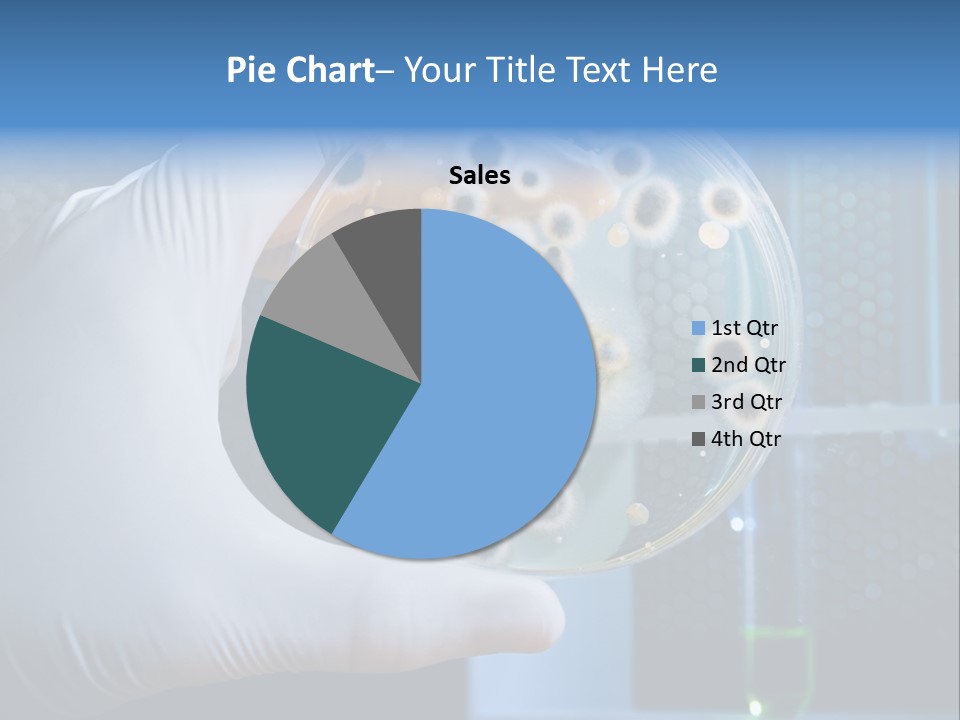
Biotechnology Medicine Analysis PowerPoint Template
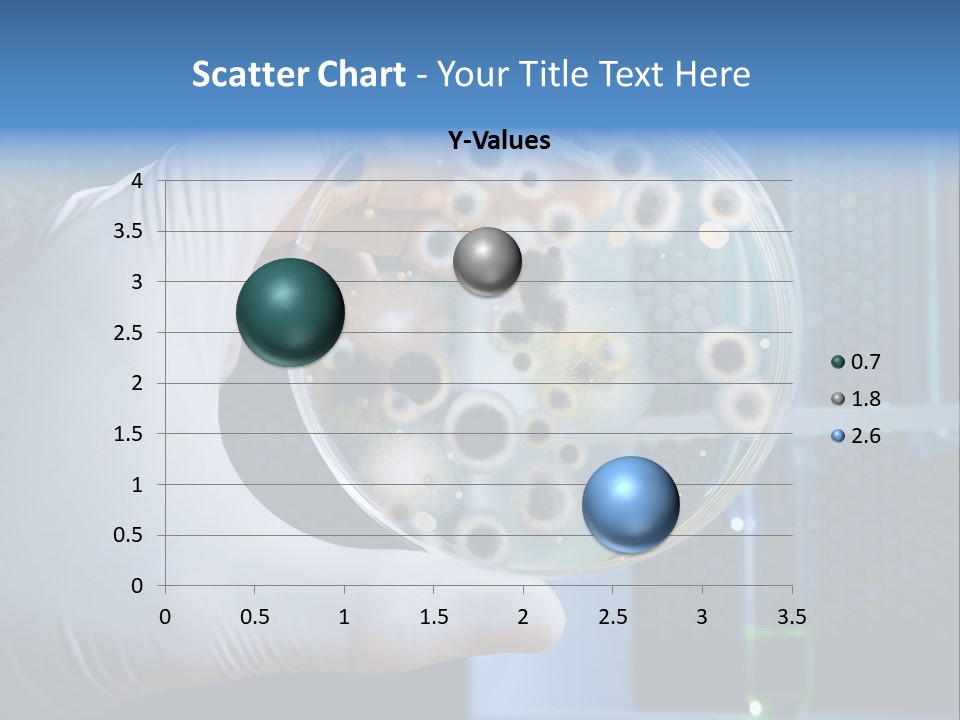
Biotechnology Medicine Analysis PowerPoint Template
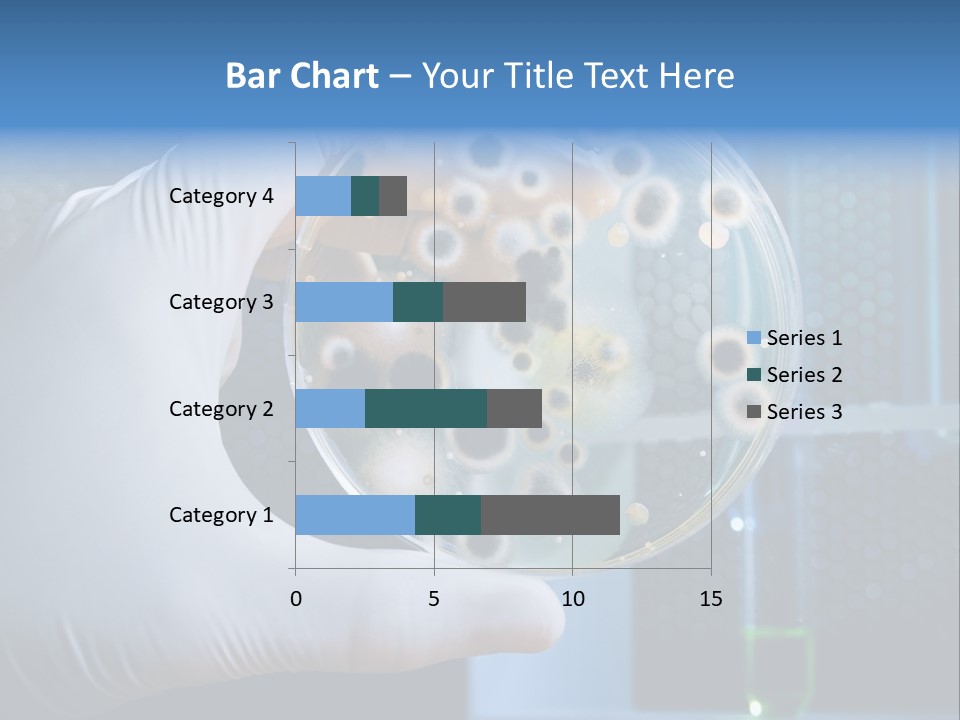
Biotechnology Medicine Analysis PowerPoint Template
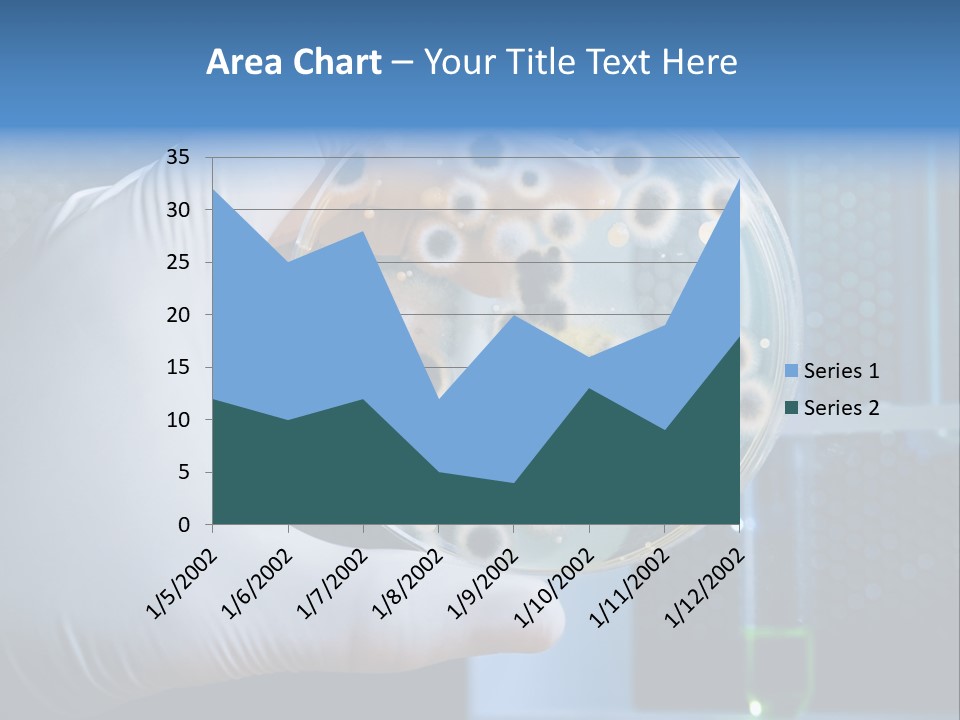
Biotechnology Medicine Analysis PowerPoint Template
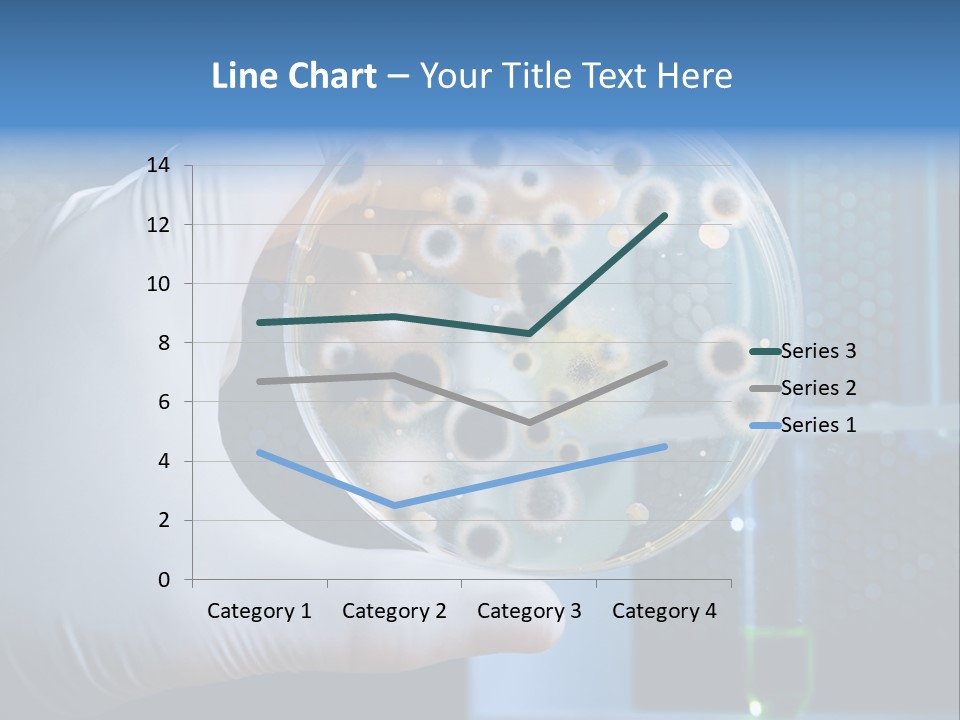
Biotechnology Medicine Analysis PowerPoint Template
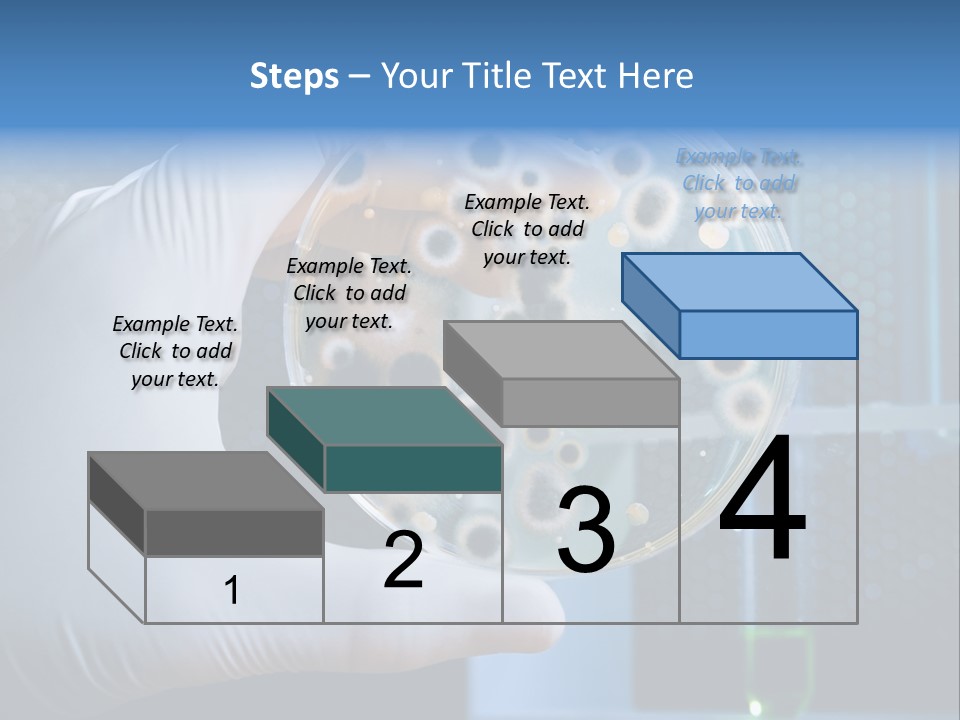
Biotechnology Medicine Analysis PowerPoint Template
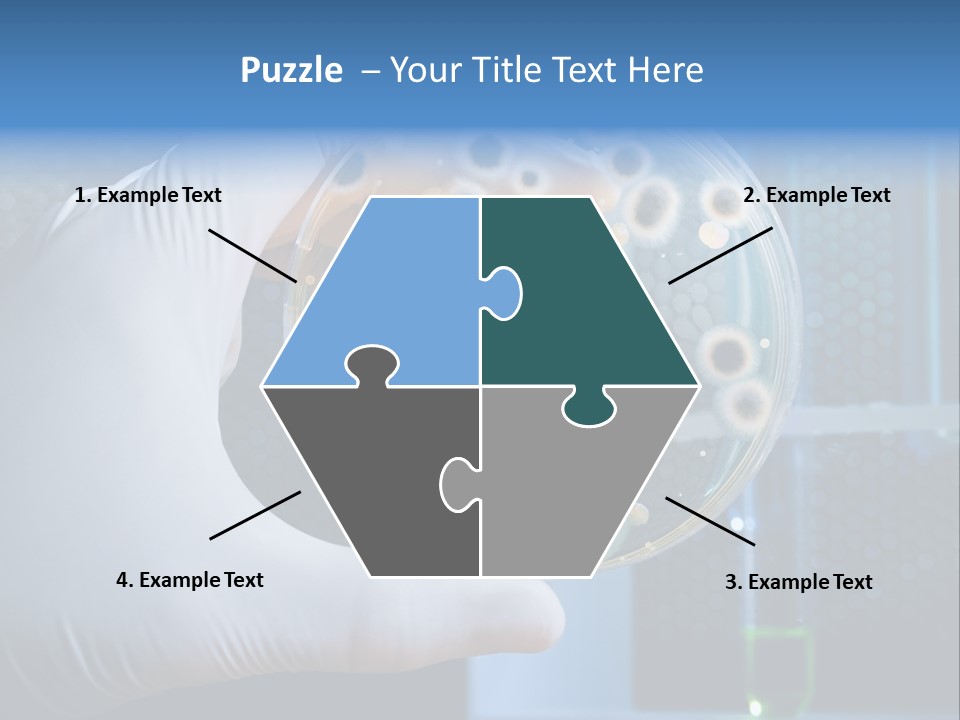
Biotechnology Medicine Analysis PowerPoint Template
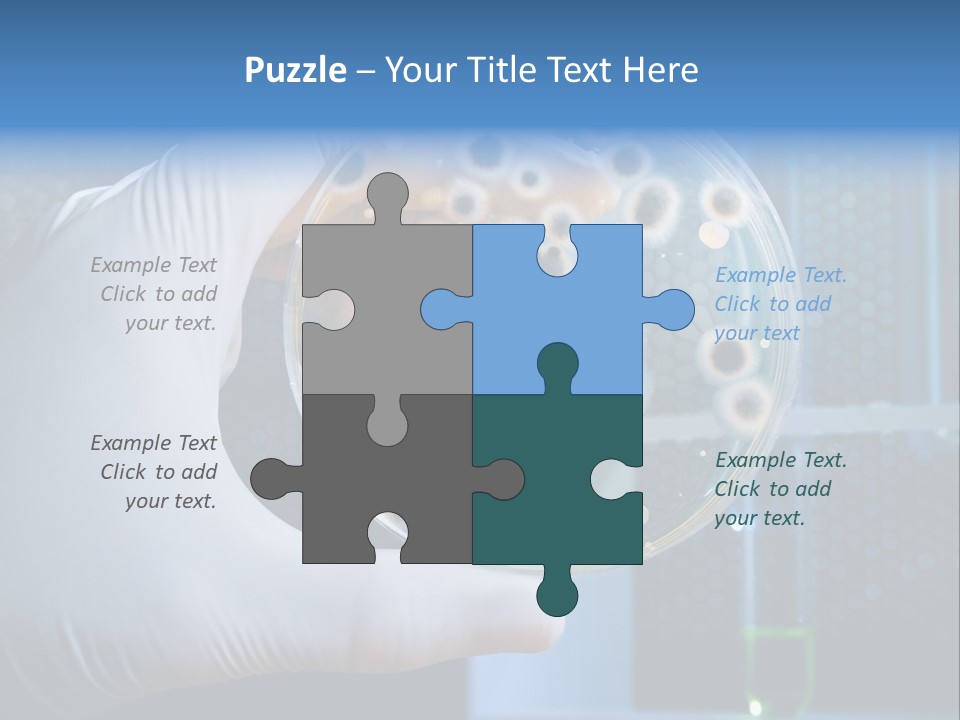
Biotechnology Medicine Analysis PowerPoint Template
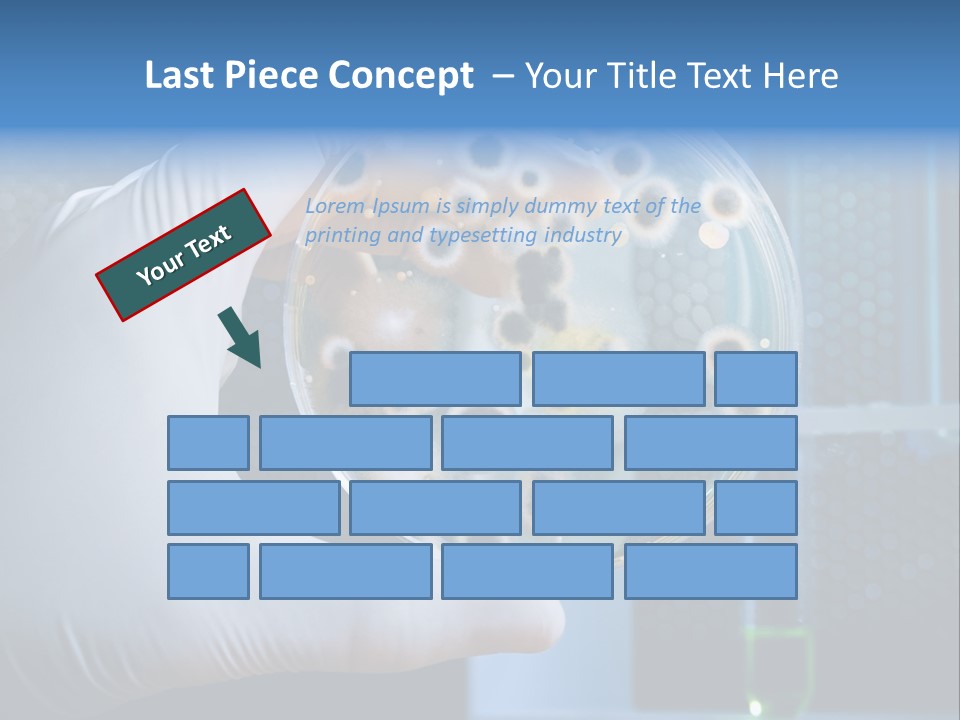
Biotechnology Medicine Analysis PowerPoint Template
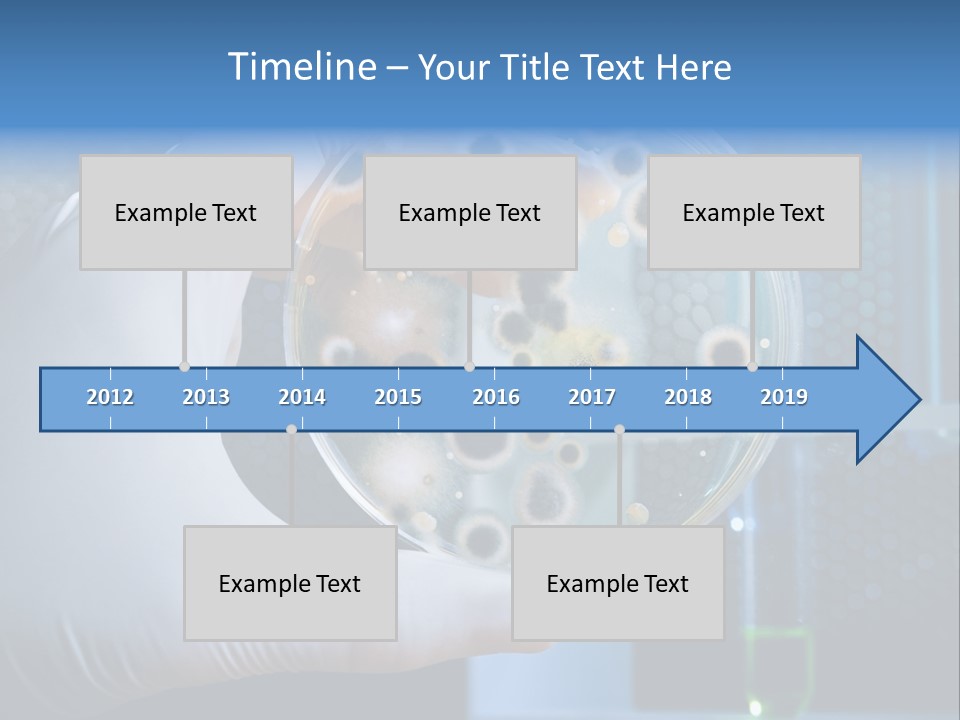
Biotechnology Medicine Analysis PowerPoint Template
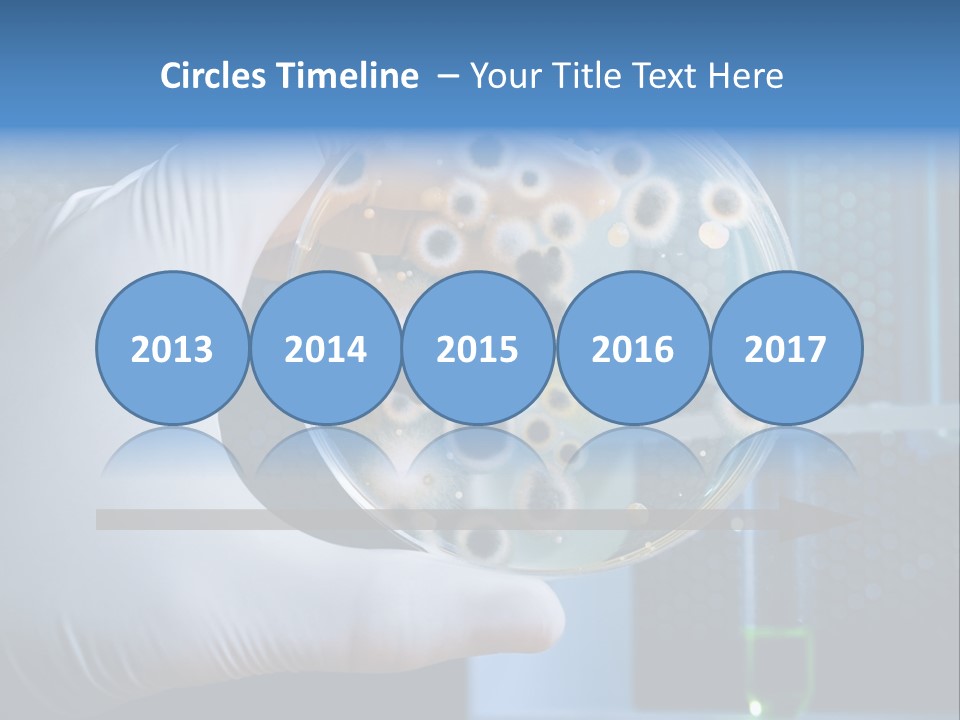
Biotechnology Medicine Analysis PowerPoint Template
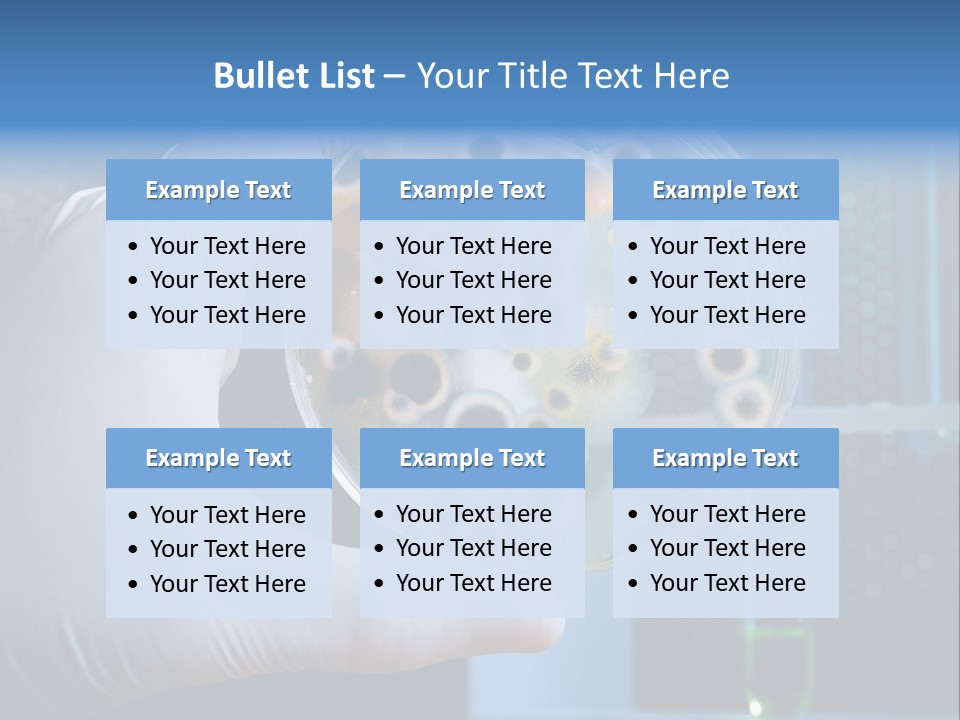
Biotechnology Medicine Analysis PowerPoint Template
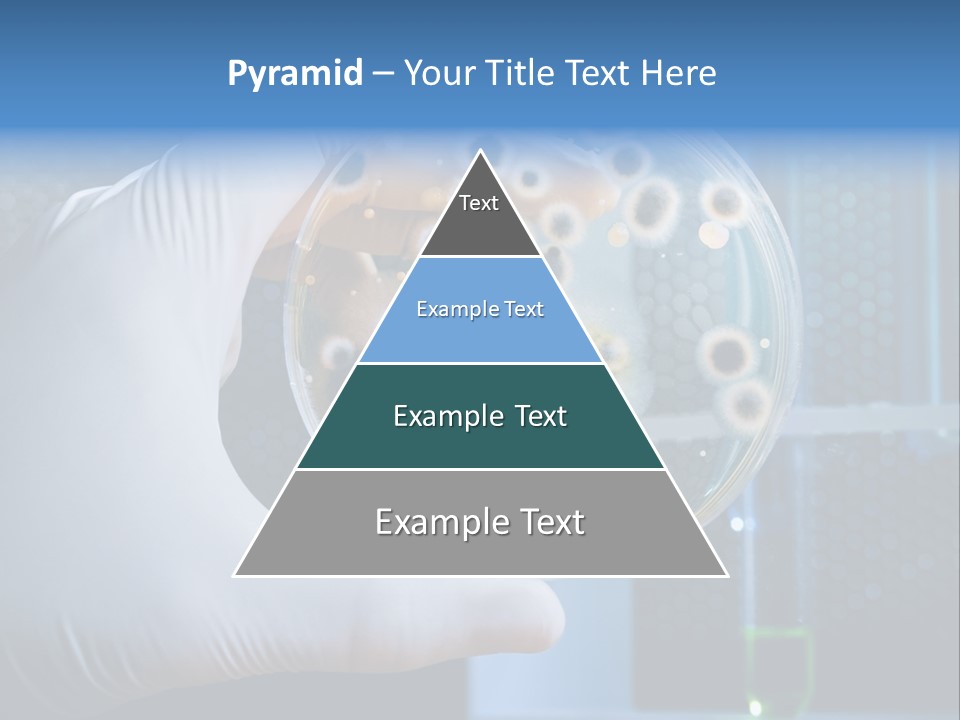
Biotechnology Medicine Analysis PowerPoint Template
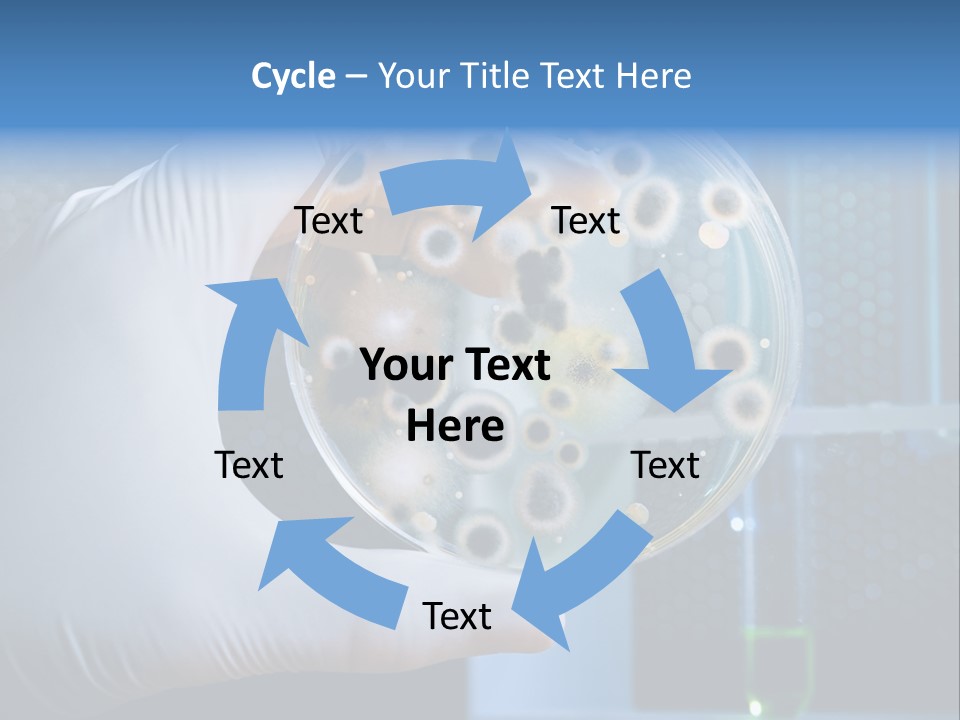
Biotechnology Medicine Analysis PowerPoint Template
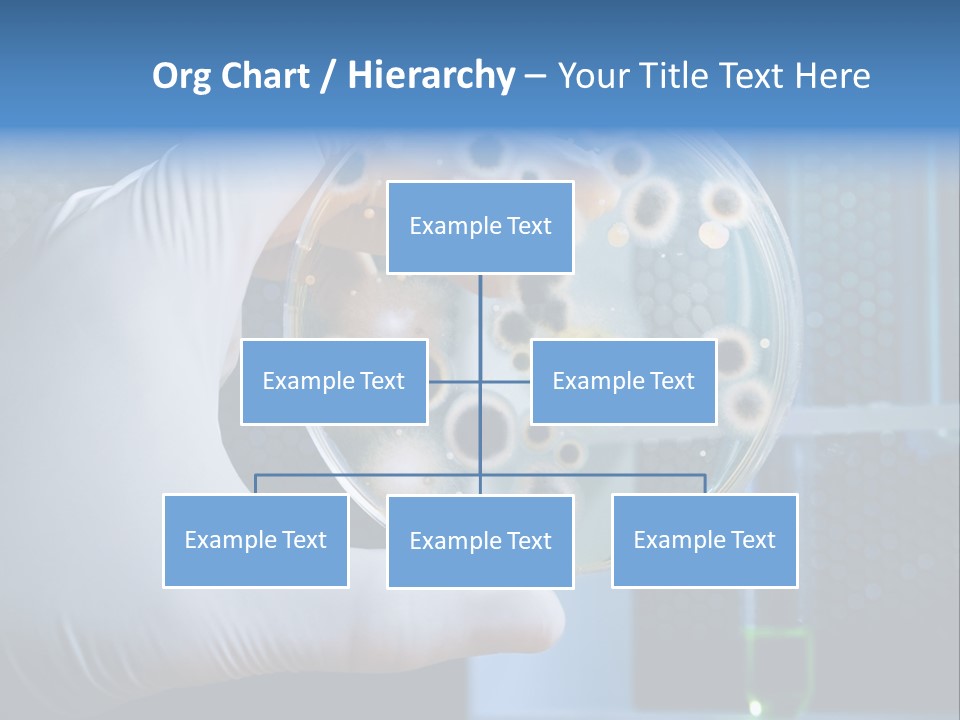
Biotechnology Medicine Analysis PowerPoint Template
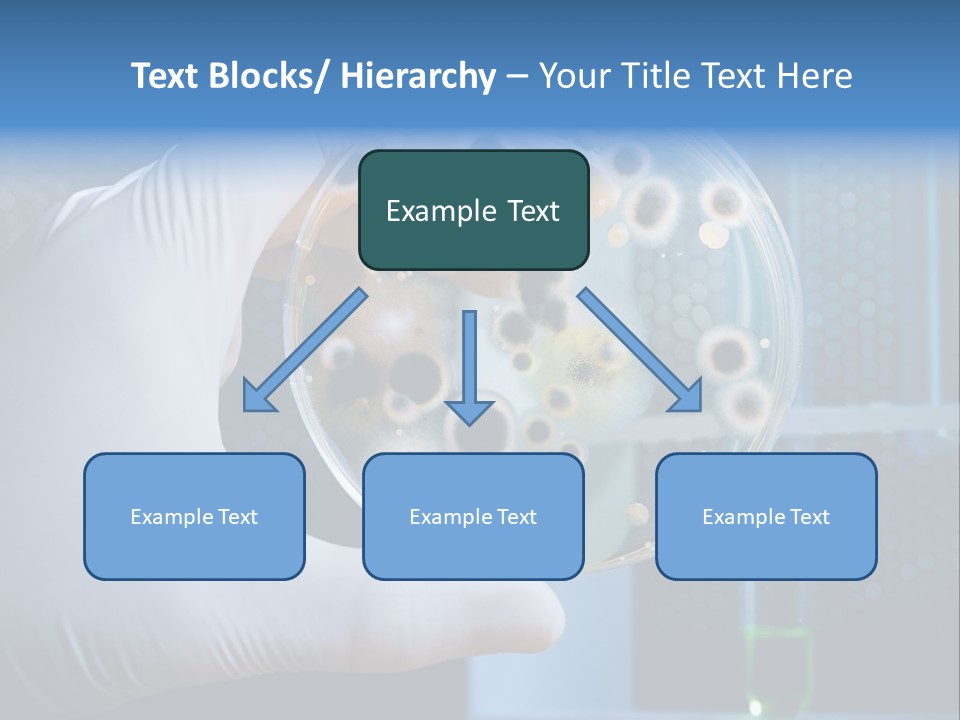
Biotechnology Medicine Analysis PowerPoint Template
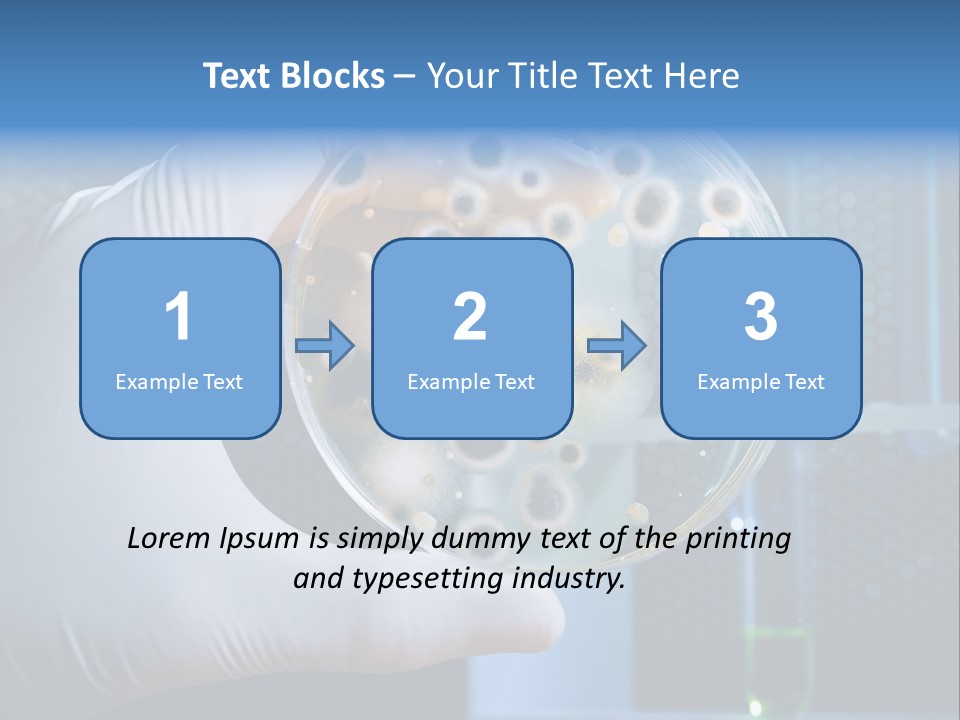
Biotechnology Medicine Analysis PowerPoint Template
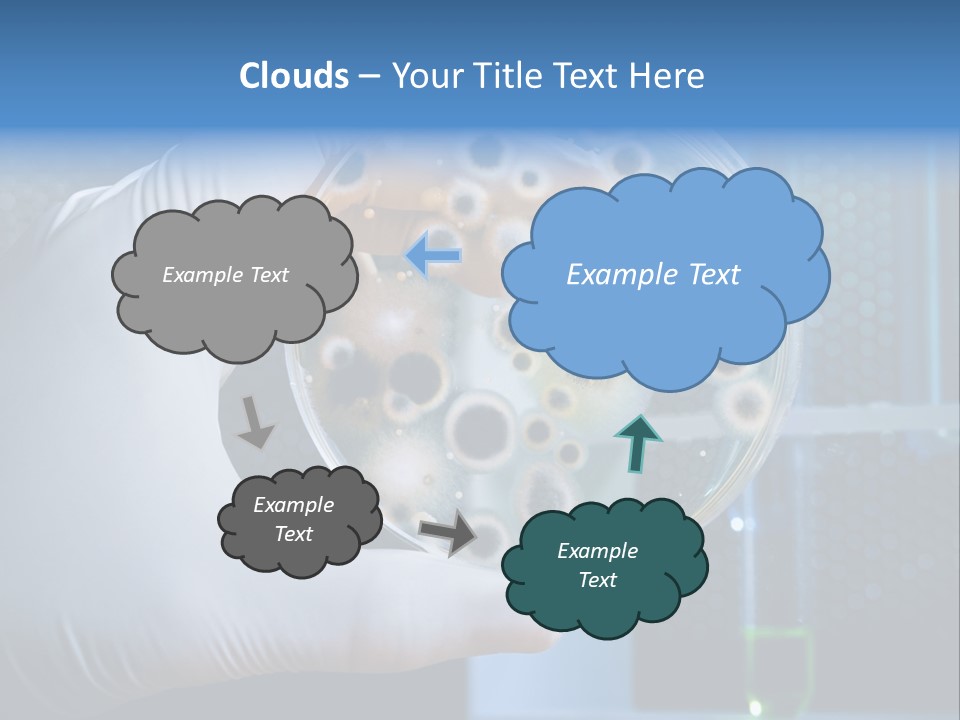
Biotechnology Medicine Analysis PowerPoint Template
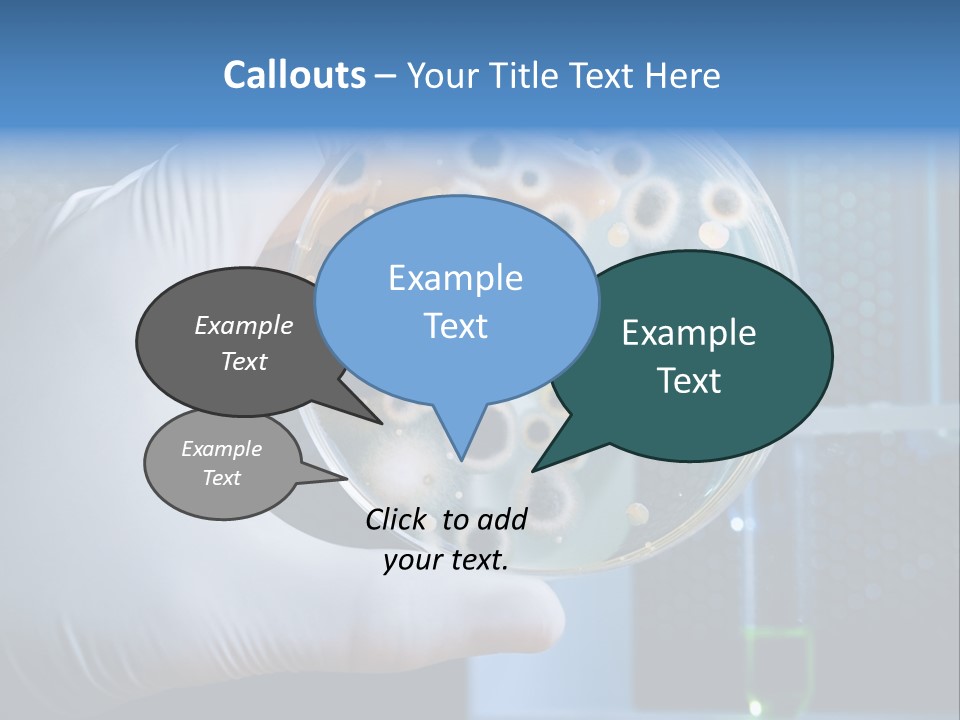
Biotechnology Medicine Analysis PowerPoint Template
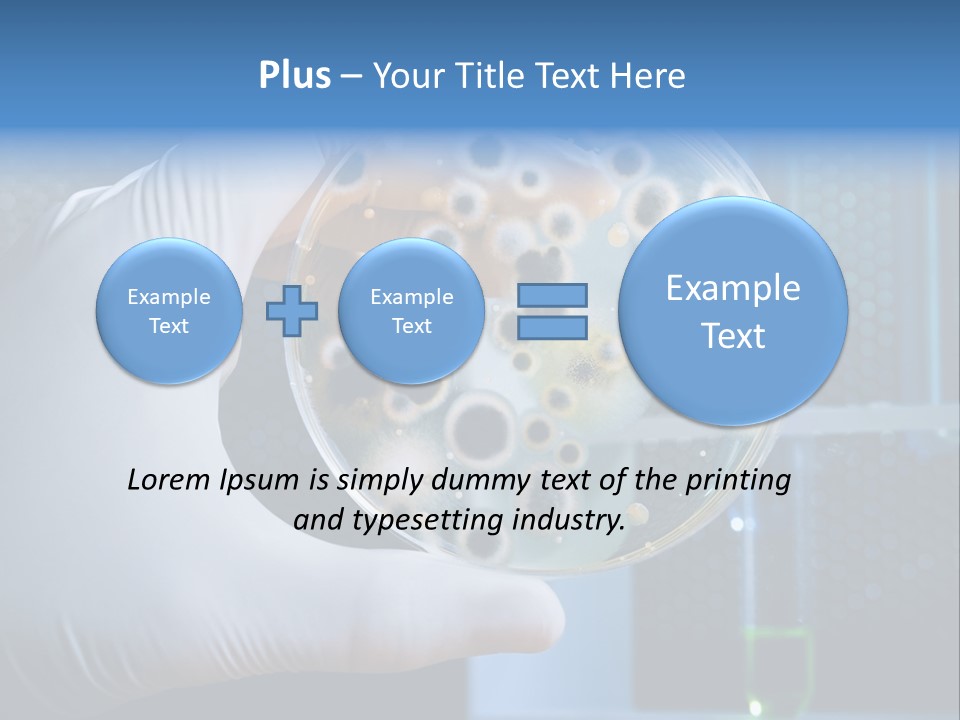
Biotechnology Medicine Analysis PowerPoint Template
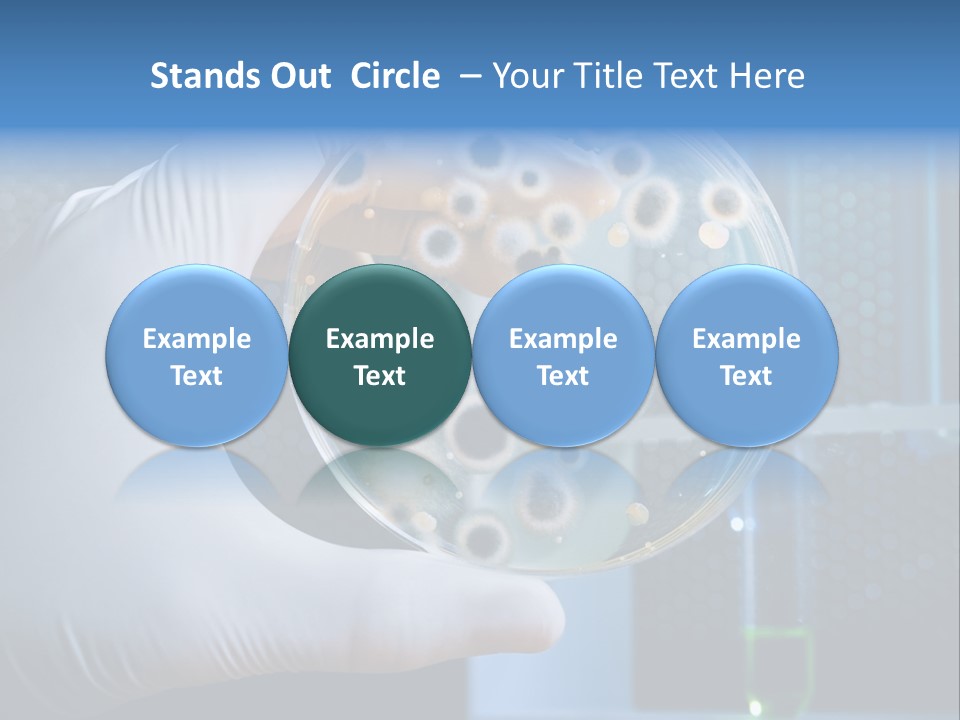
Biotechnology Medicine Analysis PowerPoint Template
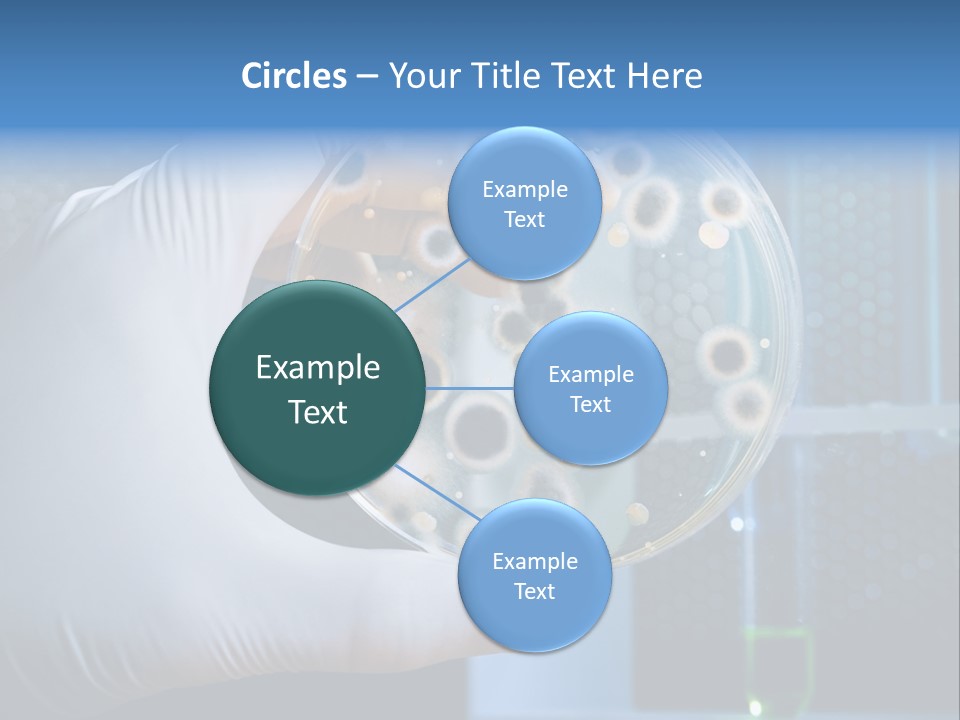
Biotechnology Medicine Analysis PowerPoint Template
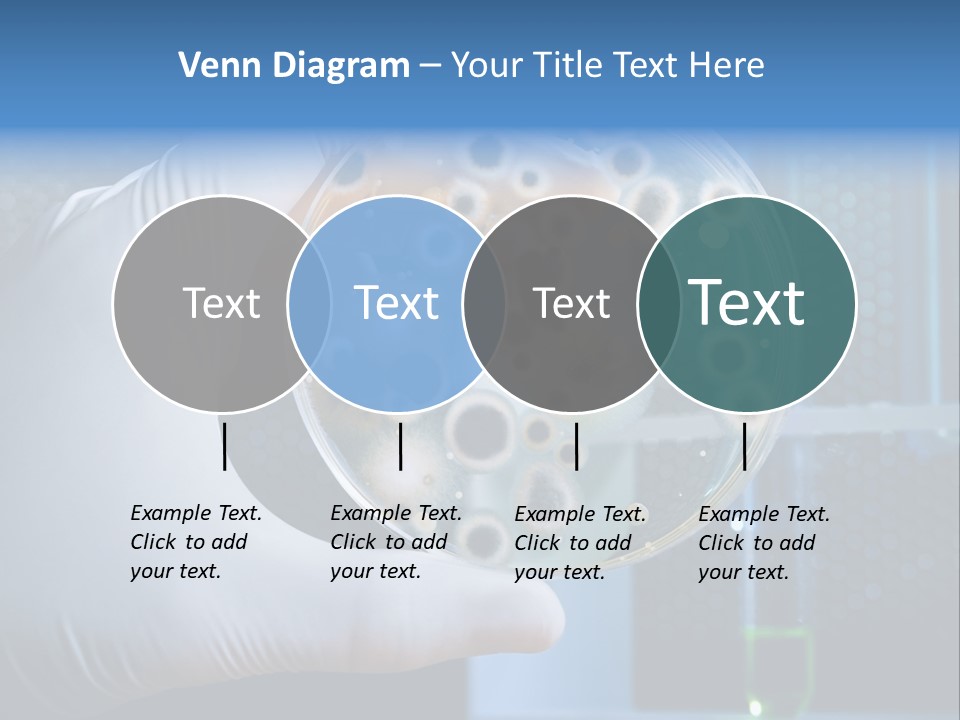
Biotechnology Medicine Analysis PowerPoint Template
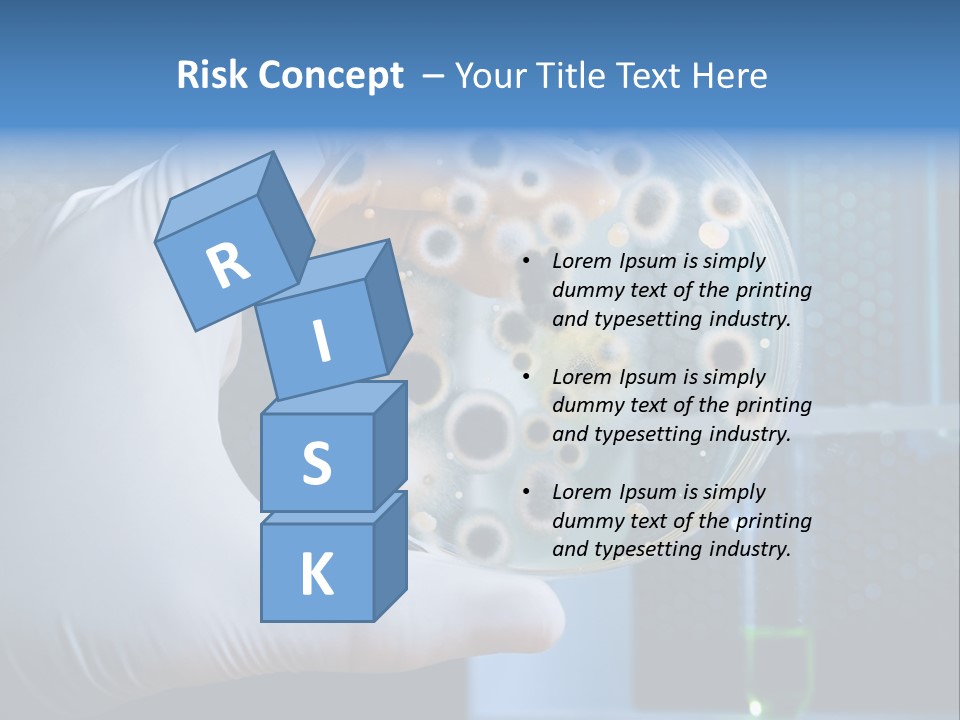
Biotechnology Medicine Analysis PowerPoint Template
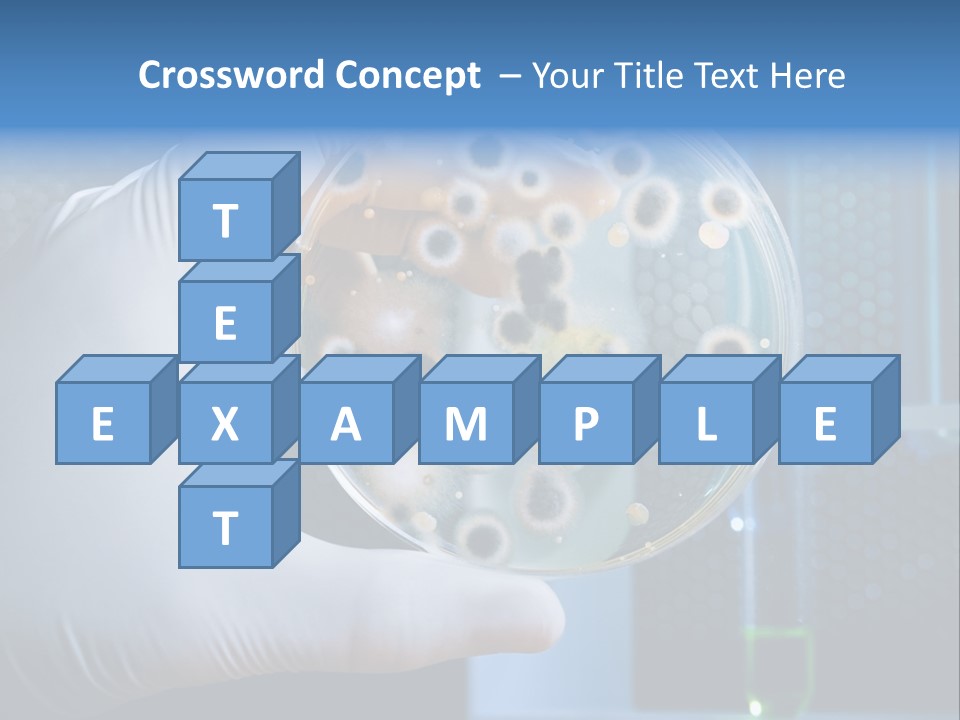
Biotechnology Medicine Analysis PowerPoint Template
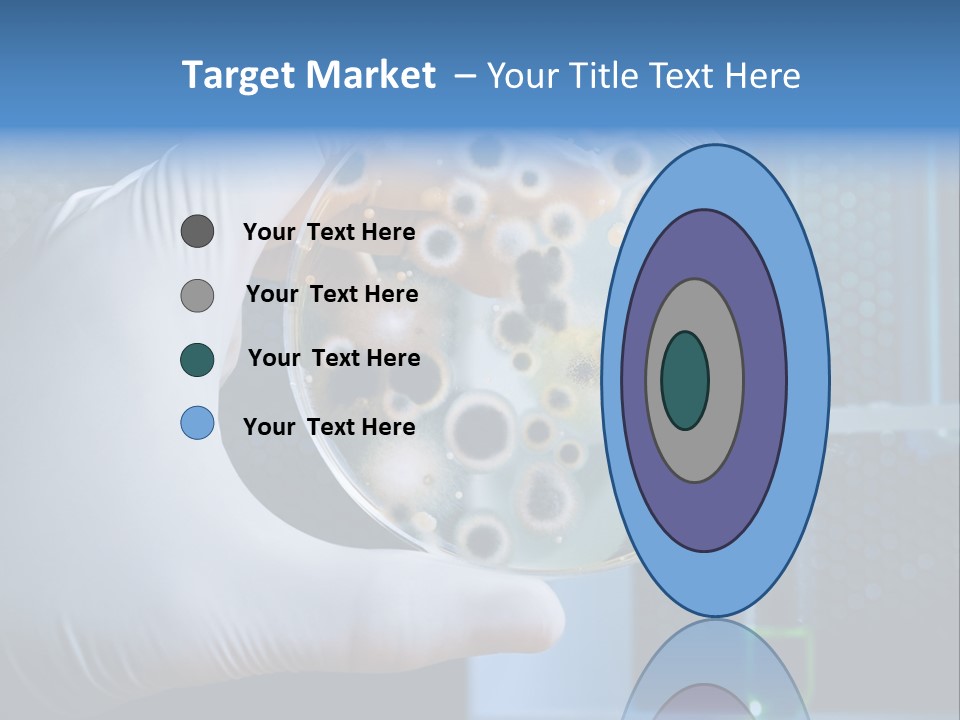
Biotechnology Medicine Analysis PowerPoint Template
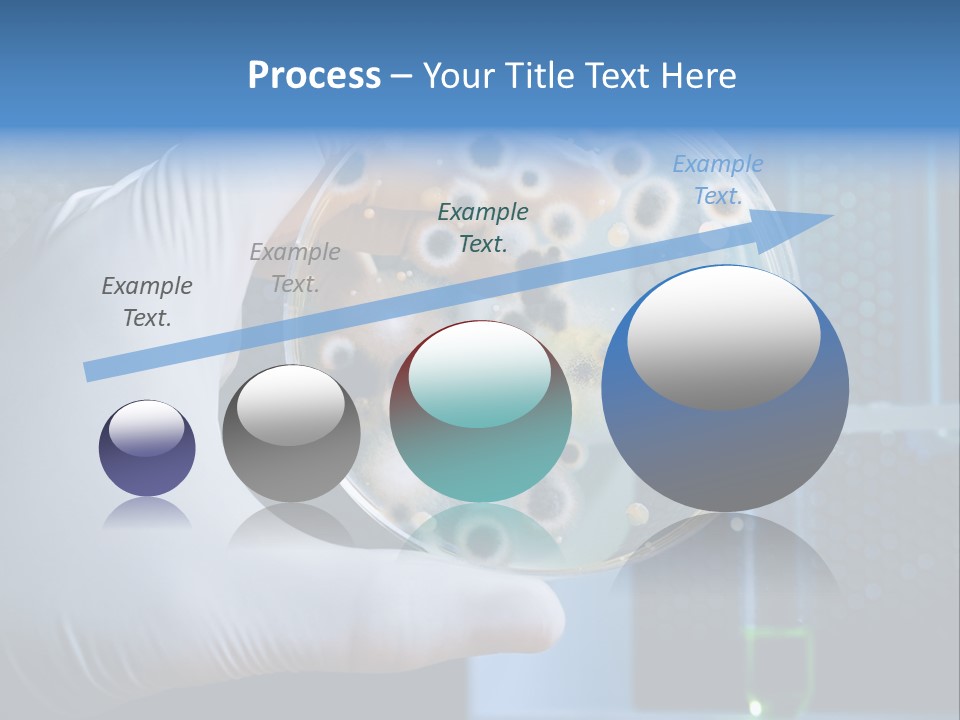
Biotechnology Medicine Analysis PowerPoint Template
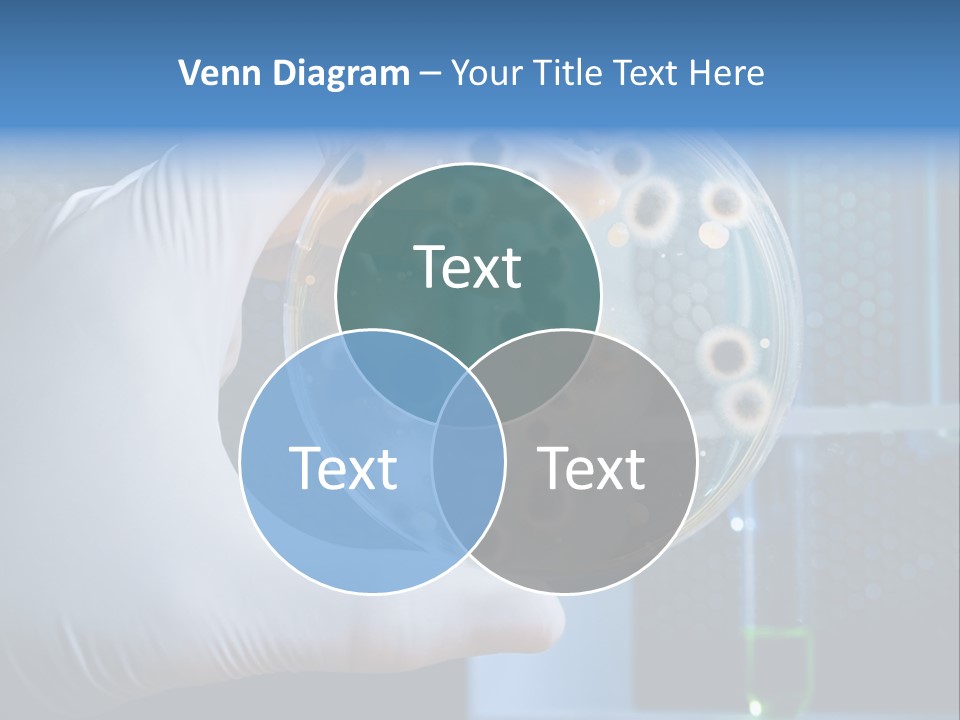
Biotechnology Medicine Analysis PowerPoint Template
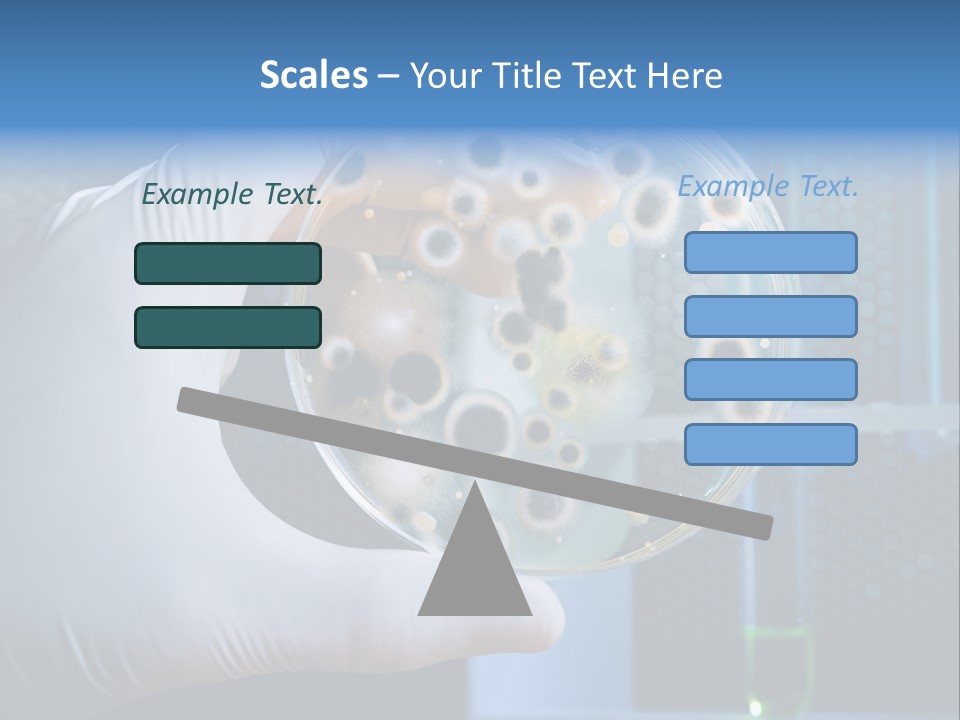
Biotechnology Medicine Analysis PowerPoint Template
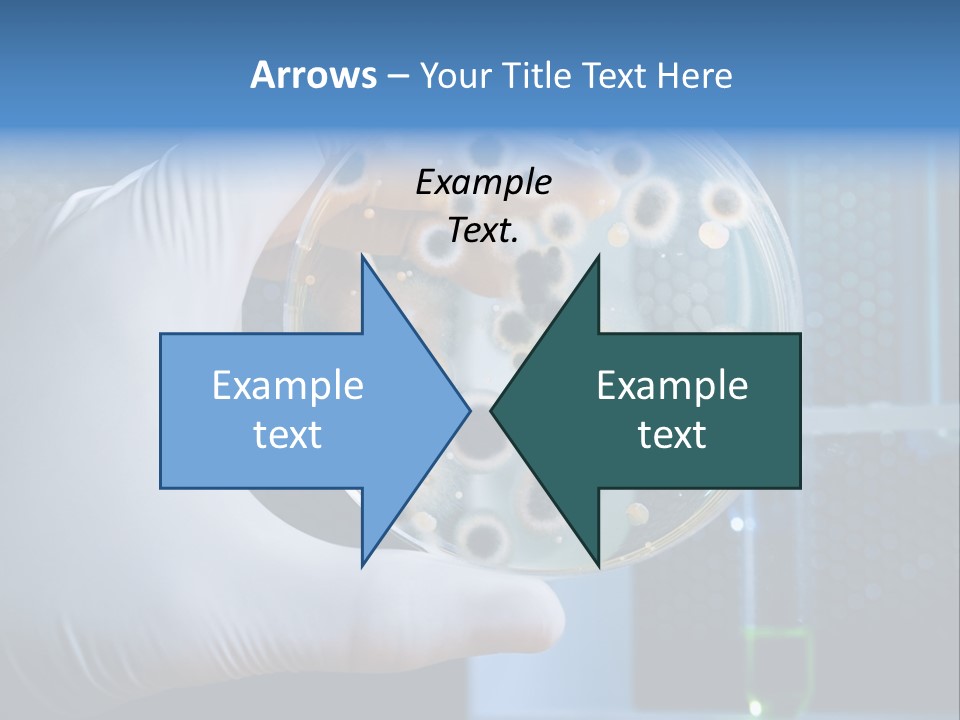
Biotechnology Medicine Analysis PowerPoint Template
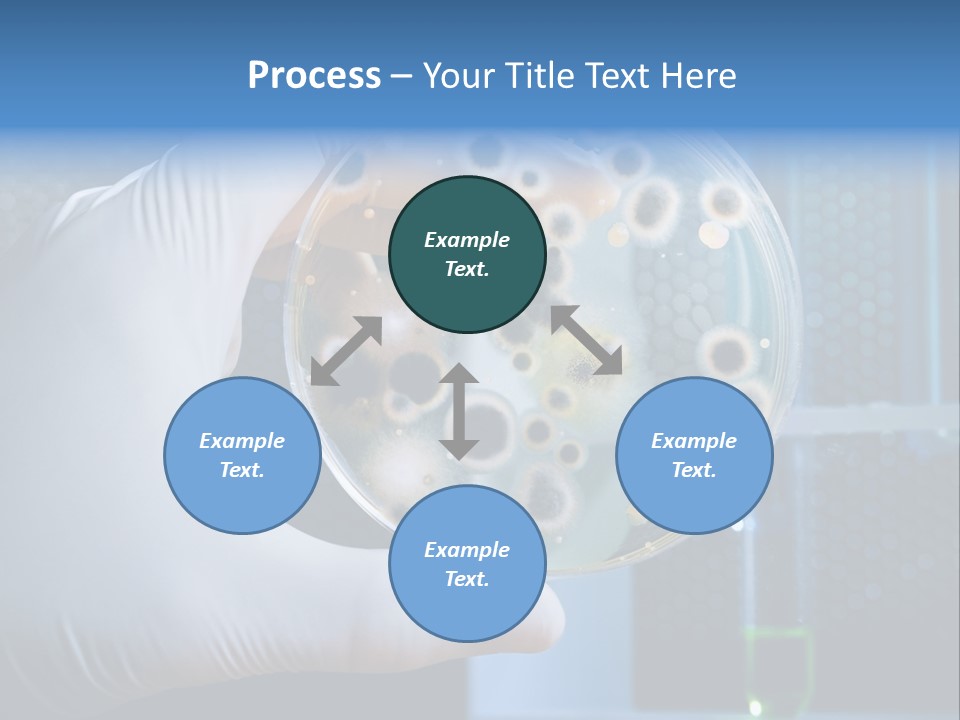
Biotechnology Medicine Analysis PowerPoint Template
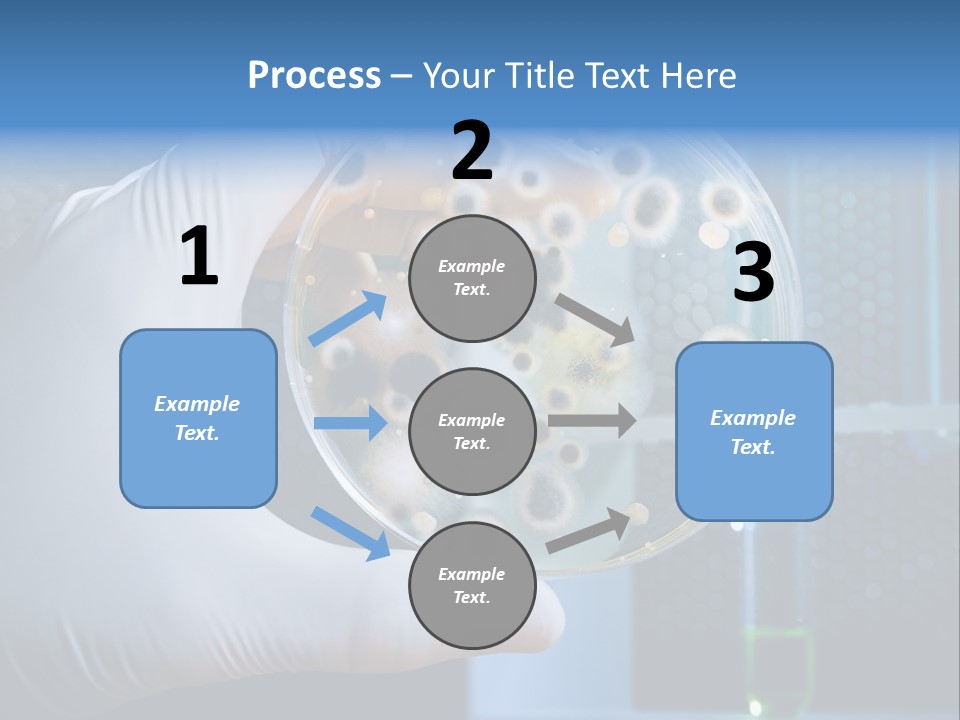
Biotechnology Medicine Analysis PowerPoint Template
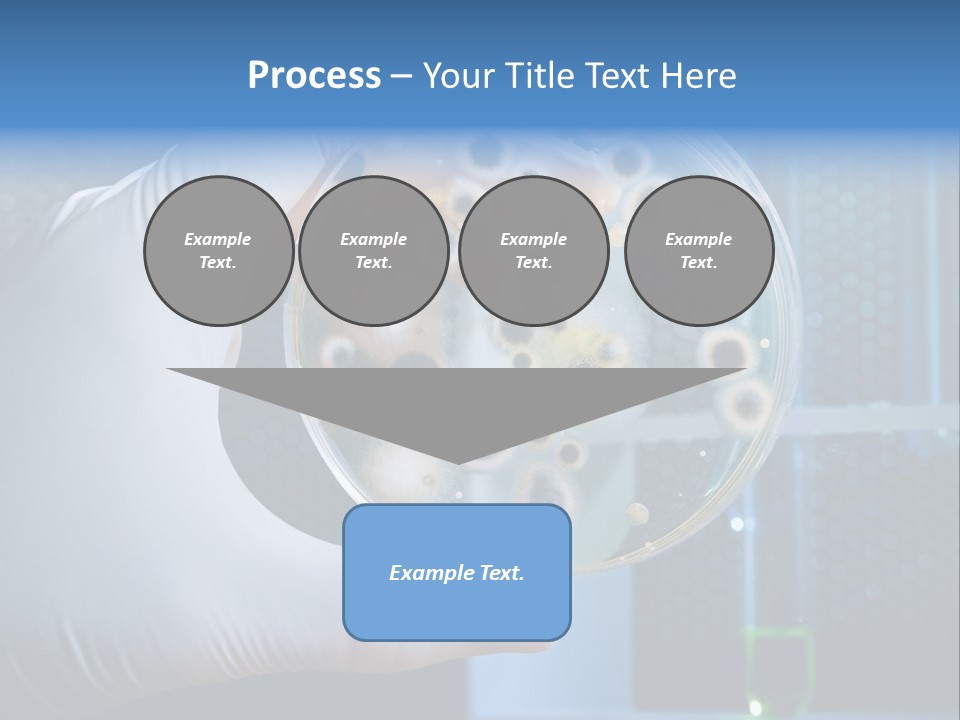
Biotechnology Medicine Analysis PowerPoint Template
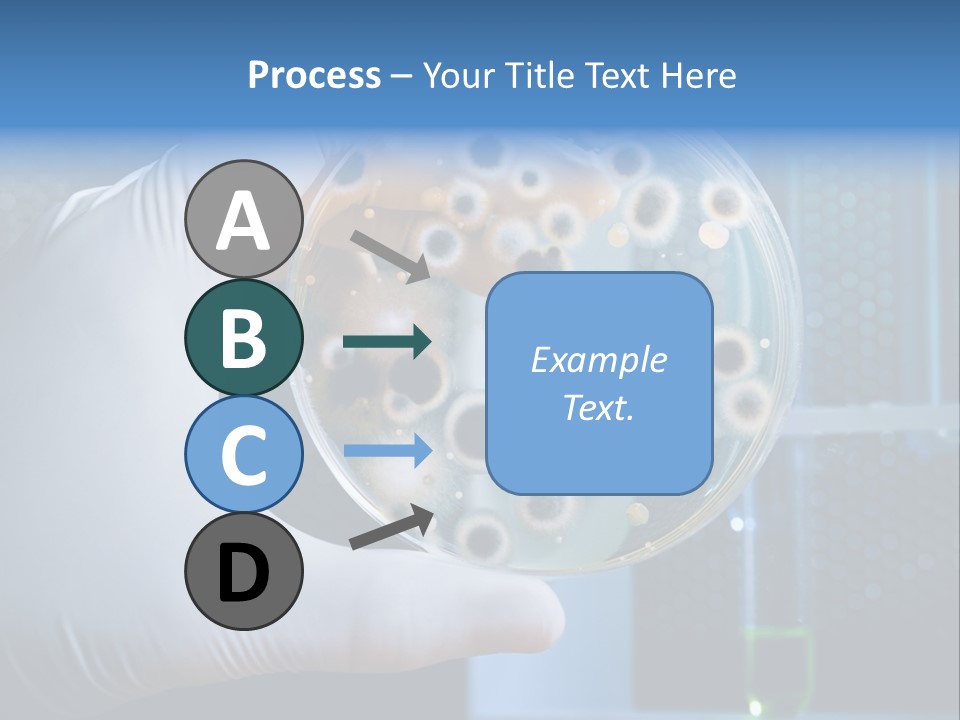
Biotechnology Medicine Analysis PowerPoint Template
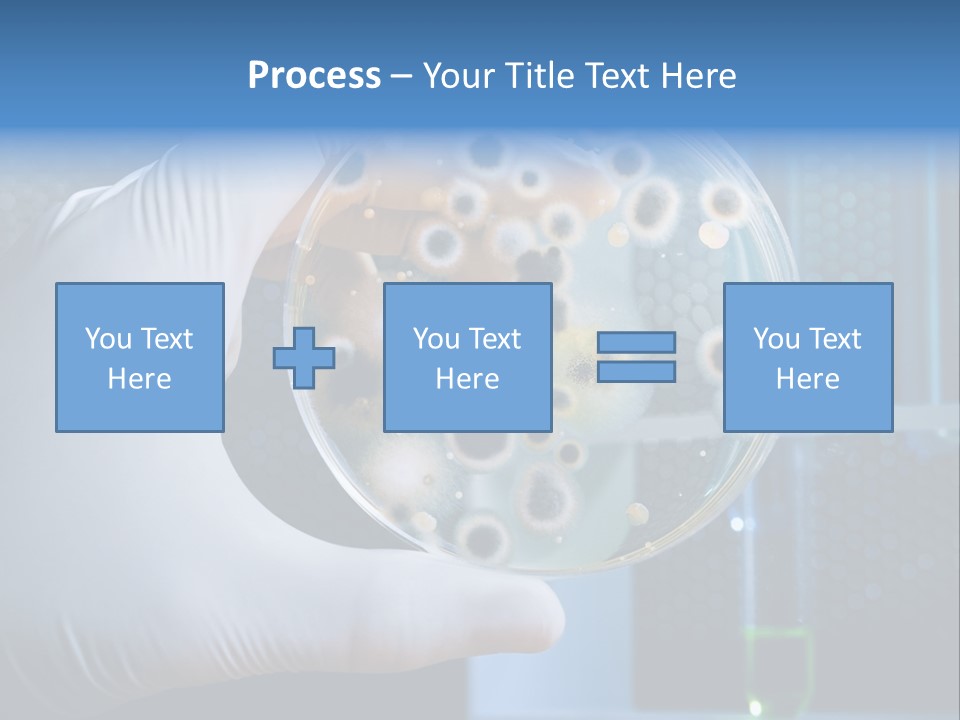
Biotechnology Medicine Analysis PowerPoint Template
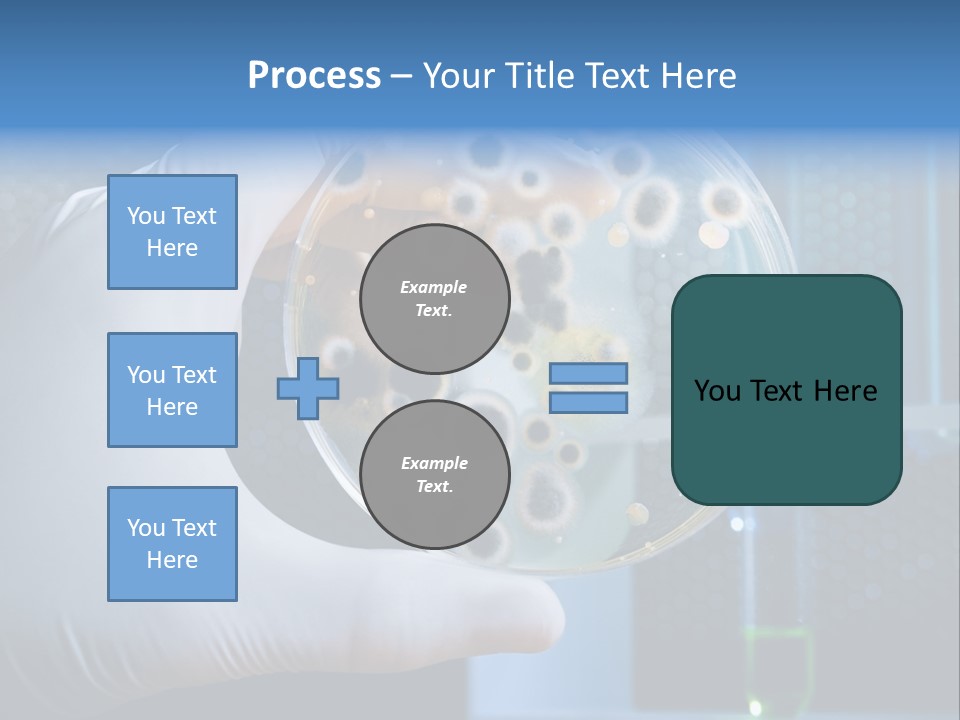
Biotechnology Medicine Analysis PowerPoint Template
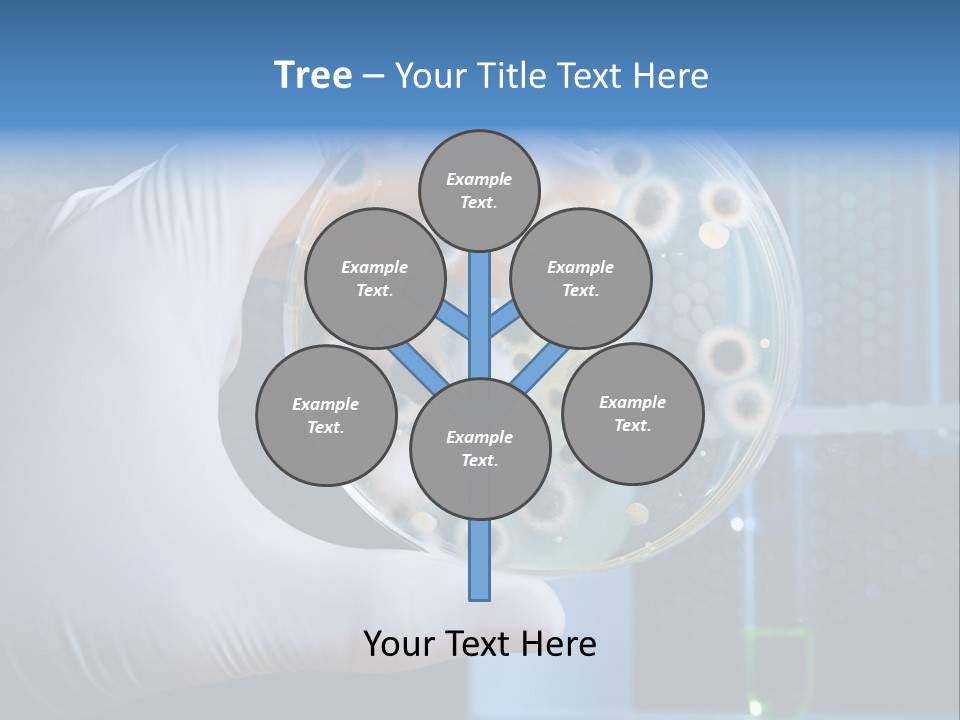
Biotechnology Medicine Analysis PowerPoint Template
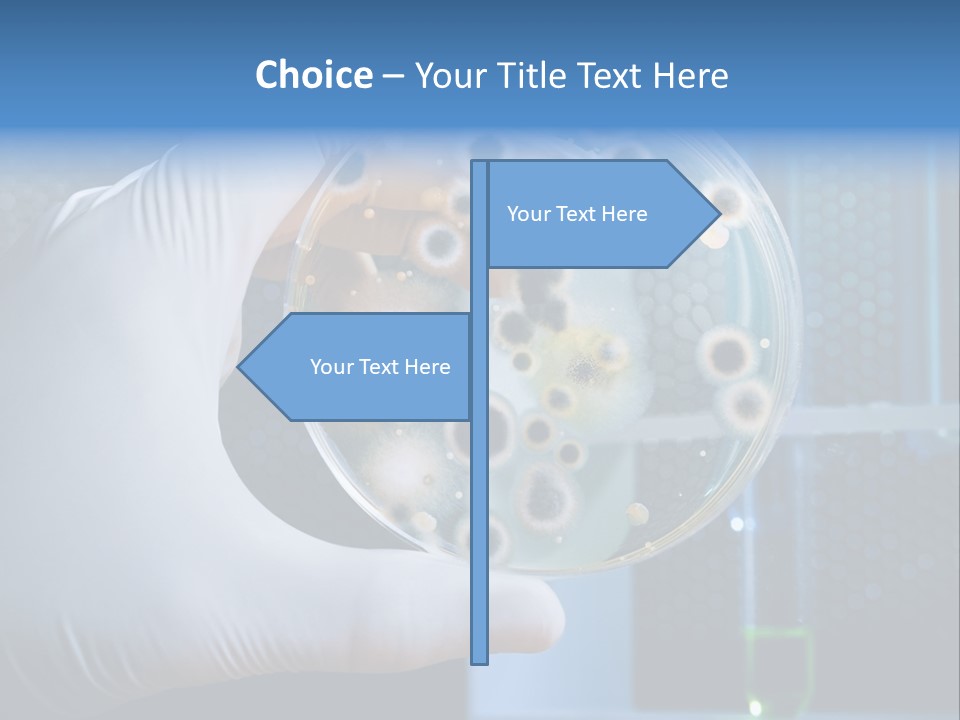
Biotechnology Medicine Analysis PowerPoint Template
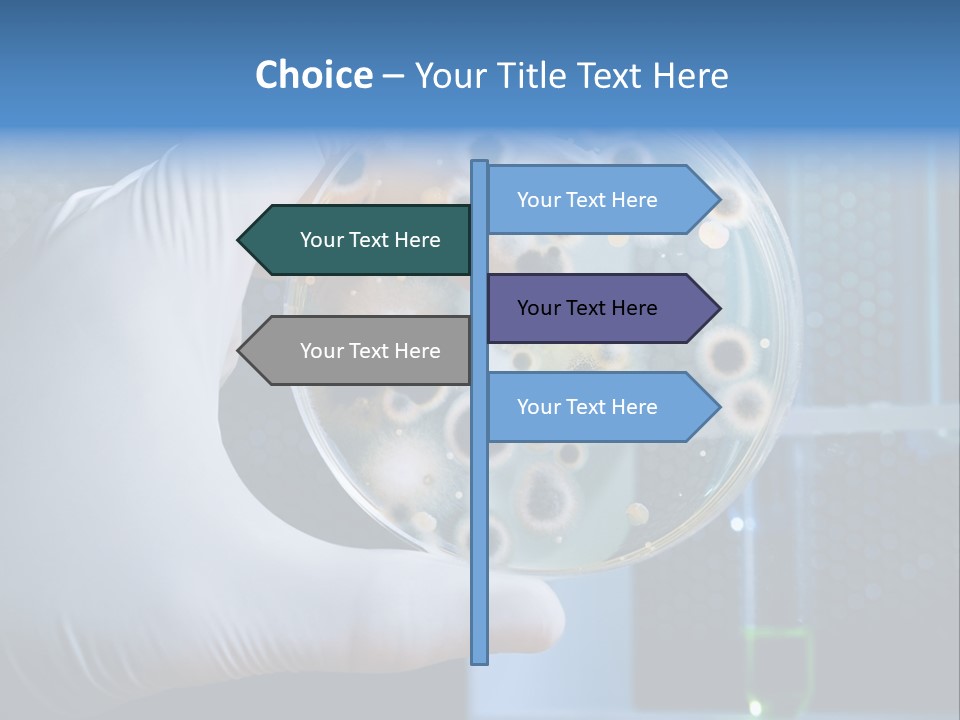
Biotechnology Medicine Analysis PowerPoint Template
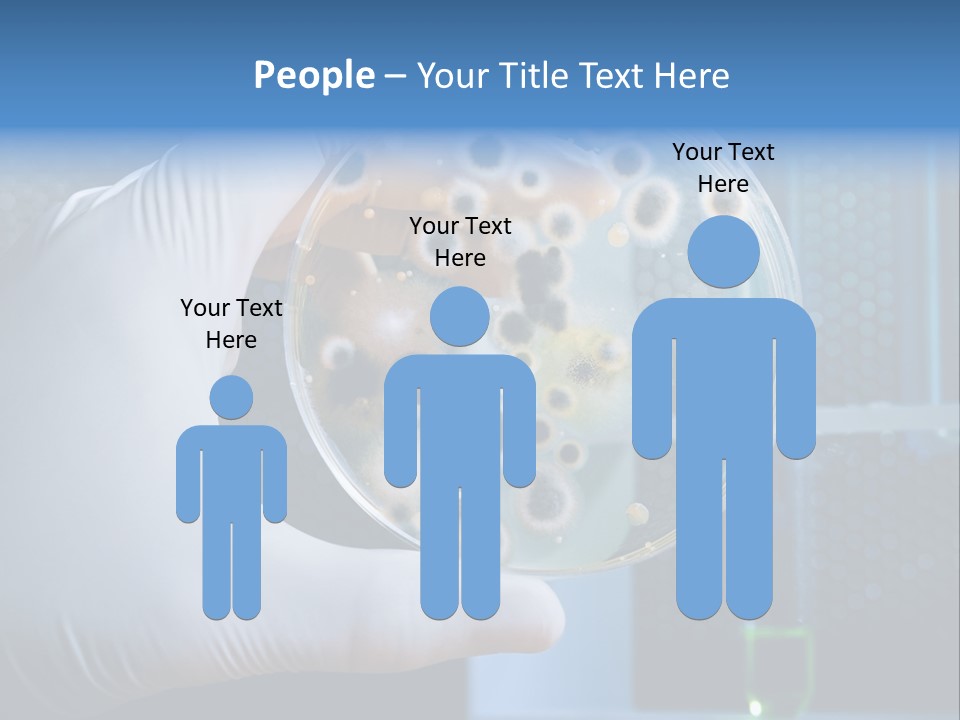
Biotechnology Medicine Analysis PowerPoint Template
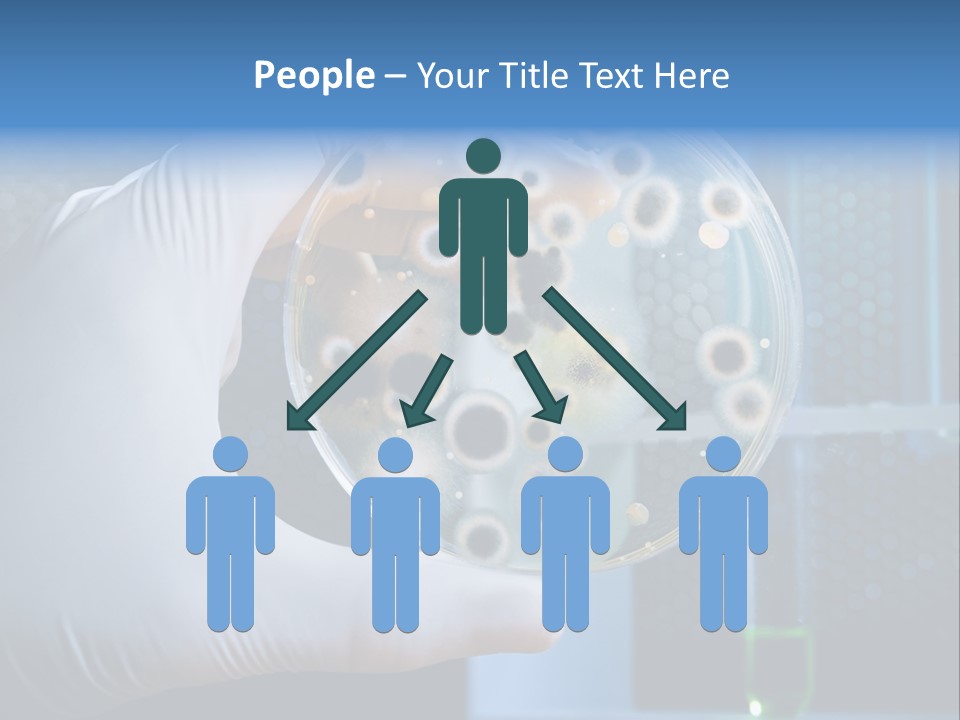
Biotechnology Medicine Analysis PowerPoint Template
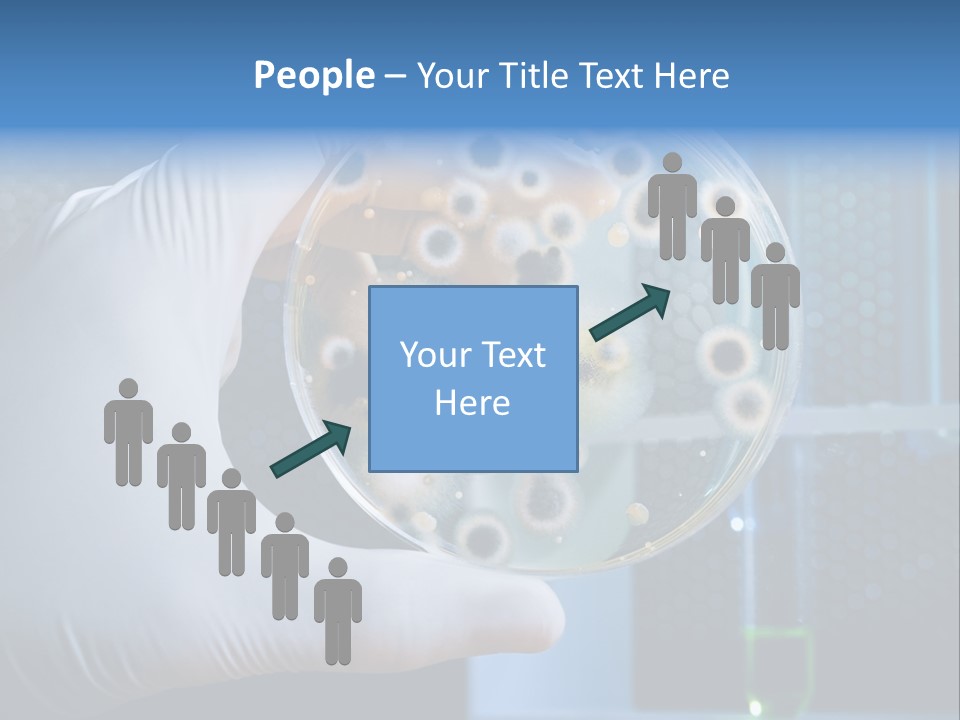
Biotechnology Medicine Analysis PowerPoint Template
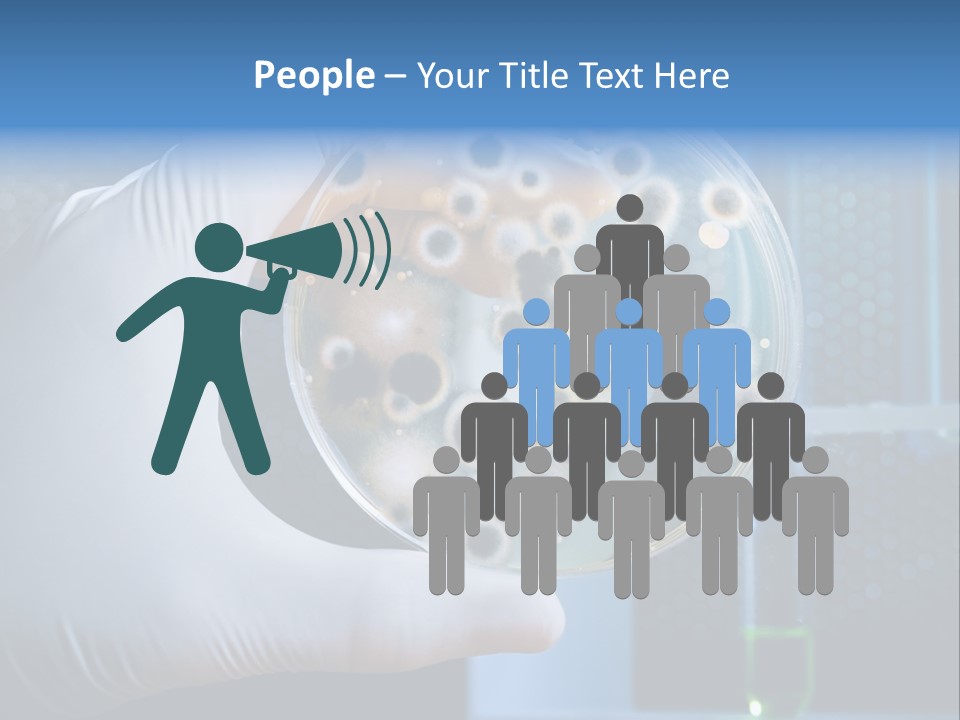
Biotechnology Medicine Analysis PowerPoint Template
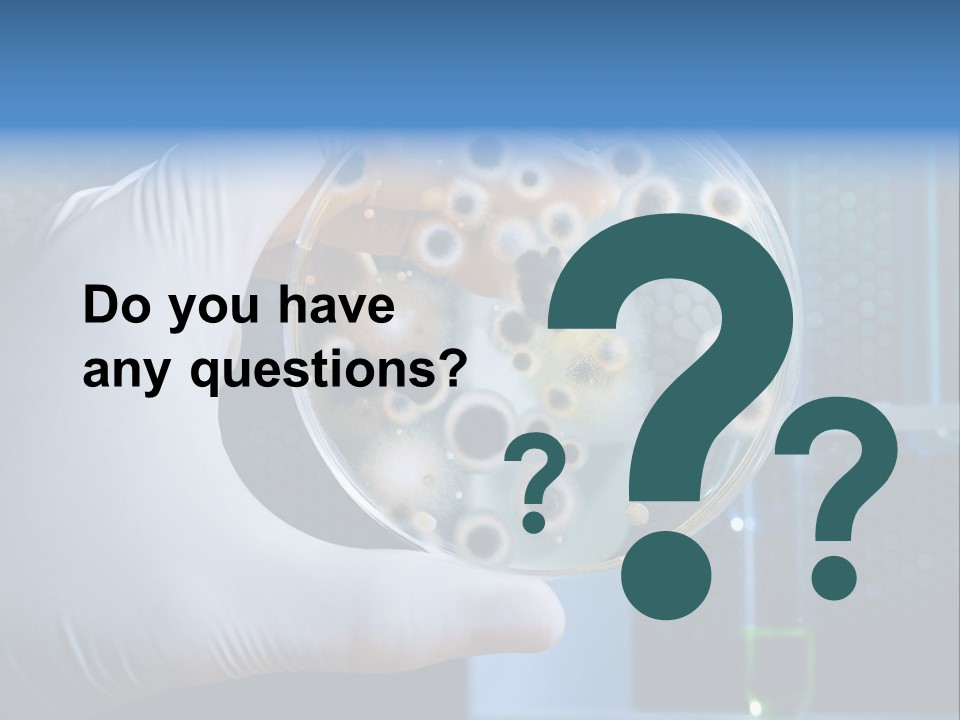
Biotechnology Medicine Analysis PowerPoint Template

ID: PPT-0000166722
Standard Stock-Templates License
Free for personal and commercial use with attribution required.
Free
3 slides
Free
90 slides
-
Slides:
3 or 90 Slides
-
Compatible with:
Microsoft PowerPoint, Google Slides, Apache OpenOffice, Apple Keynote
-
Aspect Ratio:
1024x768
4:3 @ 96 dpi (Normal),
16:9 (Widescreen) -
File Type:
PPT, PPTX
-
File Size:
1.32 MB - 1.64 MB
-
Download File Type:
ZIP
-
Created:
January 23, 2019
liquid
font
balloon
helmet
circle
pattern
electric blue
metal
auto part
kitchen utensil
glass
transparent material
ceiling
nail
fashion accessory
sphere
macro photography
party supply
lighting accessory
automotive wheel system
liquid bubble
ball
automotive lighting
light bulb
personal protective equipment
light fixture
comfort food
plastic